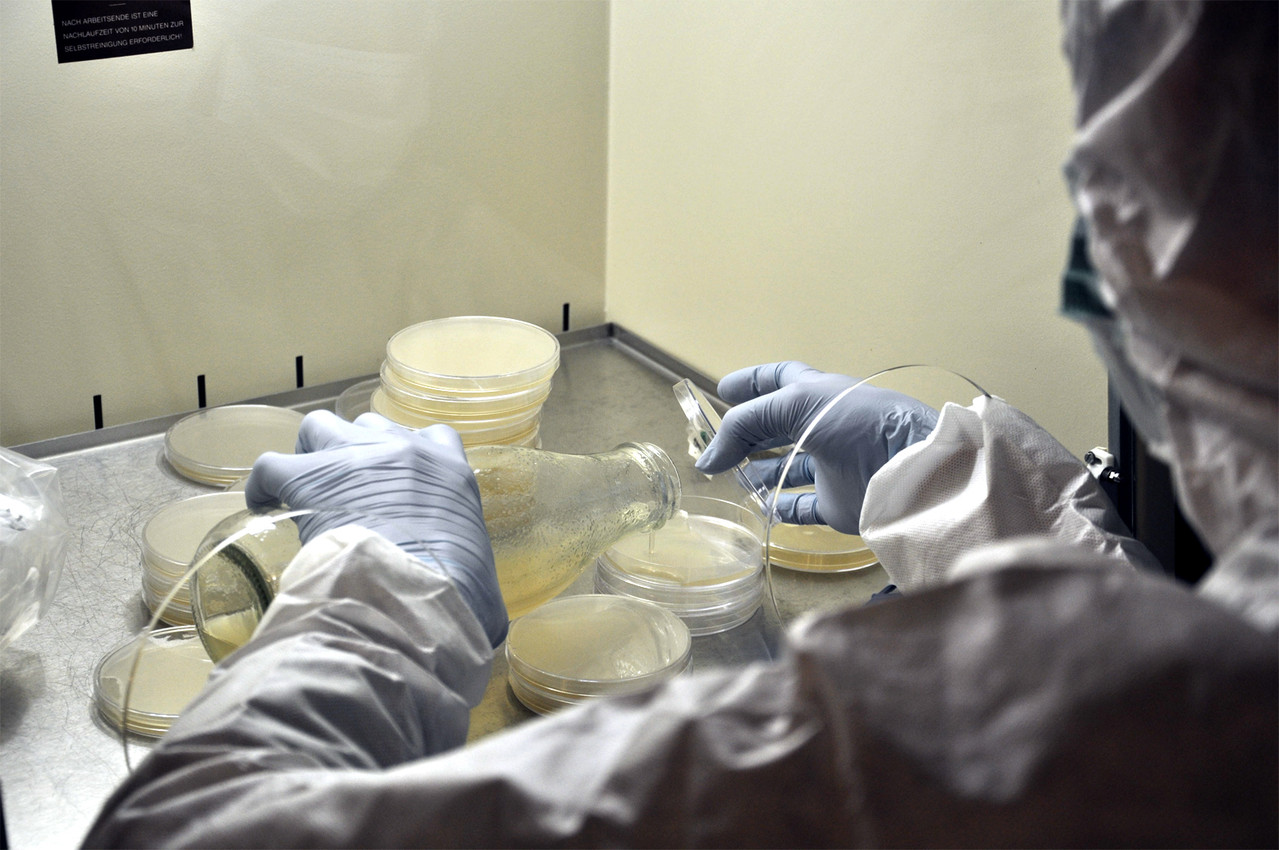
MalzextraktAgar Pulver

Malzsirup ist ein aus Gersten-Malz hergestellter, hell- bis dunkelbrauner, malzartig schmeckender Sirup, der unter anderem als Backmittel verwendet werden kann. In trockener Form wird er Malzextrakt genannt. Werden andere Getreidearten als Gerste zur Herstellung verwendet, muss deren Name vorangestellt werden.
Die im Malzextrakt enthaltenen Zucker zeigen unter Hitzeeinwirkung (Karamellisierung) charakteristische Reaktionen, die Geschmack, Farbe und das Aroma der Gebäcke intensivieren. Weiterhin trägt die Maillard-Reaktion (nicht-enzymatische Bräunung) bei, die aus Zucker und Aminosäuren gebäcktypische Reaktionsprodukte liefert. Sie sind hauptsächlich für das typische Gebäckaroma verantwortlich. Der Maltosegehalt beträgt mindestens 55 %, der Dextringehalt höchstens 12 %. Die wichtigsten Aromasubstanzen sind Maltol und 3-Methylbutanal. Flüssiges und getrocknetes Malzextrakt wird als Nähr- und Stärkungsmittel angeboten.
Herstellung
- Schroten von Malz (vorwiegend aus Gerste)
- Herstellen einer Maische (mit Wasser angerührt)
- Wiederholtes Ziehen lassen (50–72 °C, knapp anderthalb Stunden), wasserlösliche Verbindungen entstehen
- Abläutern (=abtrennen von unlöslichem Treber)
- Vakuumverdampfer entzieht schonend Wasser (Lagerfähigkeit)
- Je nach gewünschter Verwendung wird die verbliebene Enzymaktivität durch Erhitzen auf 78 °C deaktiviert. (Bei der Herstellung von Backmalz unterbleibt dieser Schritt)
- sirupöse Substanz
Verwendung
- Getrocknetes Backmalz wird in Backmischungen, Backmitteln und Fertigmehlen eingesetzt.
- Durch seinen süßen Geschmack eignet sich Malzextrakt aber auch für Bonbons, als Brotaufstrich oder Süßungsmittel.
- Des Weiteren ist Malzextrakt Bestandteil vieler Nährmedien, die in der Mikrobiologie Verwendung finden, so z. B. in GYM-Medium.
- Malzextrakt ist – ebenso wie Hopfenextrakt – gemäß Reinheitsgebot ein zulässiger Zusatzstoff für Bier.
Siehe auch
- Ovomaltine
Literatur
- Bill Yenne - Guinness: The 250-Year Quest for the Perfect Pint (2007) Wiley, ISBN 978-0-470-52417-6.
Einzelnachweise